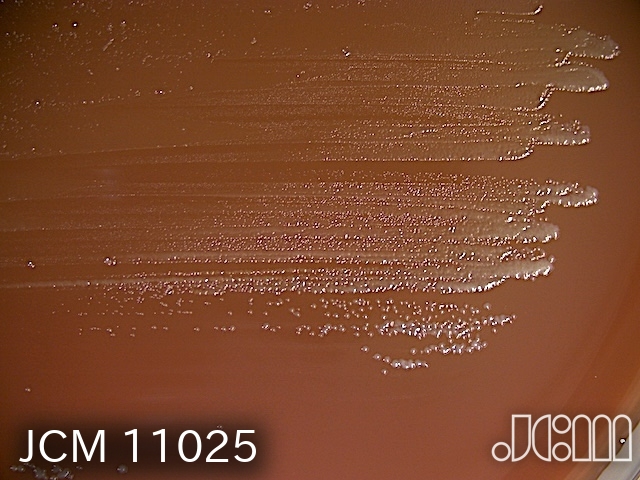

Fusobacterium animalis (Gharbia and Shah 1992) Kook et al. 2022
Taxonomy in NCBI database: Bacteria; Fusobacteria; Fusobacteriia; Fusobacteriales; Fusobacteriaceae.
11025T <-- CIP 104879 <-- NCTC 12276.
Accessioned in 2000.
=ATCC 51191 =CCUG 32879 =CIP 104879 =DSM 19679 =NCTC 12276.
Fusobacterium nucleatum subsp. animalis.
Type strain [4812,13647,13649,13650,13651].
Medium: 14; Temperature: 37°C; Anaerobic; Rehydration fluid: 663.
Morphology: [4812].
Biochemistry/Physiology: [4812].
Cell wall: meso-Lanthionine [4812].
Fatty acid: [4812].
DNA-DNA relatedness: [4812,13649].
Phylogeny: 16S rRNA gene (AB639143, GQ301042, X55404).
Other taxonomic data: Average nucleotide identity, genome-to-genome distances [13649].
Genome sequence: AFQD00000000.
More information: Glutamate dehydrogenase (GDH) [4812].
NCBI Taxonomy ID: 76859.
JCM11025